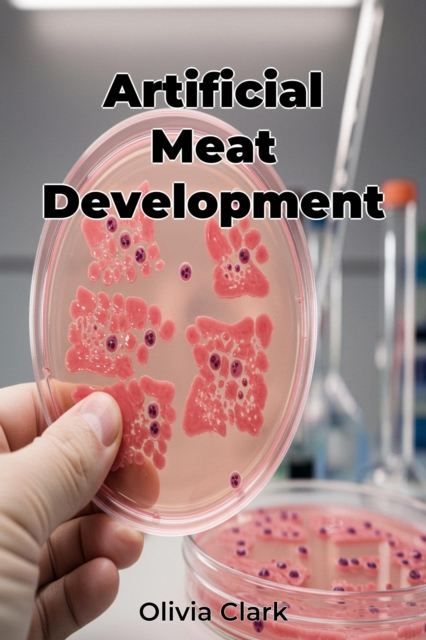
Artificial Meat Development

Artificial Meat Development
Artificial Meat Development explores the burgeoning field of lab-grown and plant-based meat alternatives, offering insights into their production, benefits, and sustainability. As global meat demand rises, these alternatives present a potential solution to the environmental and ethical issues associated with traditional animal agriculture. Did you know that traditional meat production significantl...
Artificial Meat Development explores the burgeoning field of lab-grown and plant-based meat alternatives, offering insights into their production, benefits, and sustainability. As global meat demand rises, these alternatives present a potential solution to the environmental and ethical issues associated with traditional animal agriculture. Did you know that traditional meat production significantl...
